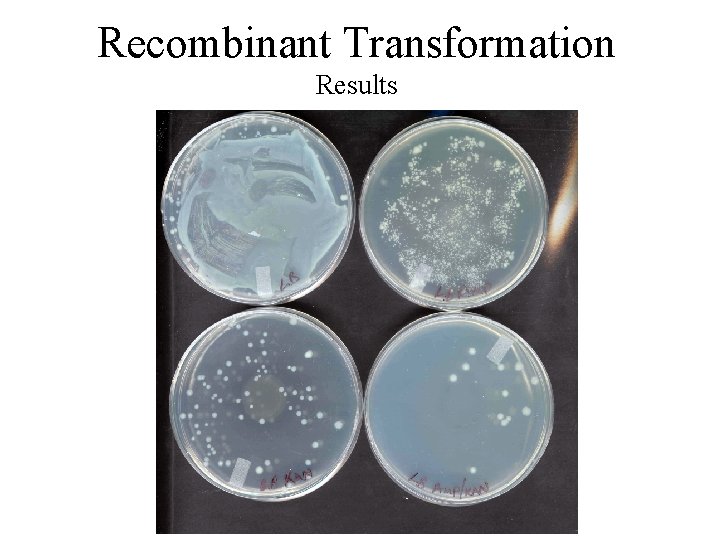
Recombinant Transformation Results Recombinant Transformation Results

Recombinant DNA Bacterial Transformation Student Instructions Transformation Recombinant

Recombinant DNA Bacterial Transformation Student Instructions Transformation

Recombinant Transformation Finger flick (vortex) tube “CC” to resuspend cells.

Recombinant Transformation Open the tube of competent cells labeled “CC” and add 20 µl of the ligation solution “Lig” directly to the “CC” tube solution using a micropipettor and sterile tip. Close the tube.

Recombinant Transformation Place the tube on ice for 15 minutes.

Recombinant Transformation Remove the tube from the ice and immediately hold it in a 42 o. C water bath for 90 seconds. Place the tube directly back on ice for 1 minute.

Recombinant Transformation Use a sterile pipette to add 10 drops of sterile LB nutrient broth to the competent cell “CC” tube. Close the tube. Mix by tipping the tube and inverting it gently.

Recombinant Transformation Incubate the mixture for 3 -4 hours at 37 o. C. If necessary, the mixture can be held in the refrigerator overnight.

Recombinant Transformation Label your LB agar plates with your name and date and arrange them in the following order: LB Amp/Kan LB Amp LB Kan LB

Recombinant Transformation After the incubation period, use a fresh sterile transfer pipet to draw all the cell suspension from the competent cell “CC” tube into the pipet. Place 3 drops of cell suspension onto the center of each of the four petri dishes. Always start with the LB Amp/Kan plate and end with the LB plate. See diagram below.

Recombinant Transformation Use a fresh sterile paper clip to spread the liquid evenly across the surface of each plate. Be careful not to touch the part of the paper clip that comes in contact with the agar.

Recombinant Transformation Incubate the plates (agar down) for 2 hours and then invert (agar up) for the next 24 -36 hours in a 37° C incubator.
Recombinant Transformation Results
- Slides: 12